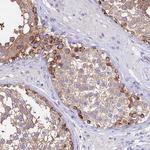
TUBA1A Antibody in Immunohistochemistry (Paraffin) (IHC (P))

Search
Invitrogen
TUBA1A Polyclonal Antibody
{{$productOrderCtrl.translations['antibody.pdp.commerceCard.promotion.promotions']}}
{{$productOrderCtrl.translations['antibody.pdp.commerceCard.promotion.viewpromo']}}
{{$productOrderCtrl.translations['antibody.pdp.commerceCard.promotion.promocode']}}: {{promo.promoCode}} {{promo.promoTitle}} {{promo.promoDescription}}. {{$productOrderCtrl.translations['antibody.pdp.commerceCard.promotion.learnmore']}}
产品信息
PA5-83674
种属反应
宿主/亚型
分类
类型
抗原
偶联物
形式
浓度
规格
纯化类型
保存液
内含物
保存条件
运输条件
RRID
产品详细信息
Immunogen sequence: ATYAPVISAE KAYHEQLSVA EITN
Highest antigen sequence indentity to the following orthologs: Mouse - 100%, Rat - 100%.
靶标信息
Alpha Tubulin is a part of a heterodimer consisting of alpha and beta tubulin subunits. The alpha and beta tubulins, which are each about 55 kDa MW, are homologous but not identical. Alpha-beta tubulin heterodimer is the basic building block of microtubules, and this intracellular cylindrical filamentous structure is present in almost eukaryotic cells. Microtubules serve as structural supports and lines of transport within the cell, as well as serving a key role in mitosis. Microtubules of the eukaryotic cytoskeleton perform essential and diverse functions and are composed of a heterodimer of alpha and beta tubulins. The alpha and beta tubulins represent the major components of microtubules, while gamma tubulin plays a critical role in the nucleation of microtubule assembly. There are multiple alpha and beta tubulin genes, which are highly conserved among species. The gene that encodes alpha tubulin is highly similar to the mouse and rat Tuba1 gene. Northern blotting studies have shown that the gene expression is predominantly found in morphologically differentiated neurologic cells.
仅用于科研。不用于诊断过程。未经明确授权不得转售。
篇参考文献 (0)
生物信息学
蛋白别名: alpha 1a antibody; alpha 3 antibody; Alpha-tubulin 1; Alpha-tubulin 3; alpha-tubulin 3 antibody; Alpha-tubulin isotype M-alpha-1; B-ALPHA-1 antibody; brain-specific antibody; FLJ25113 antibody; FLJ30169; H2 ALPHA; H2-ALPHA; H2ALPHA; hum-a-tub1; hum-a-tub1 antibody; hum-a-tub2; hum-a-tub2 antibody; LIS3 antibody; M40; MGC117247; MGC16435; OK/SW cl.56; OK/SW-cl.56; OK/SWcl.56; Talpha1 alpha-tubulin; TUBA1A antibody; TUBA3 antibody; TUBB1; TUBB5; Tubulin alpha-1 chain; Tubulin alpha-1A chain; tubulin alpha-1A chain antibody; Tubulin alpha-3 chain; tubulin alpha-3 chain antibody; Tubulin B-alpha-1; tubulin B-alpha-1 antibody; tubulin, alpha 1; tubulin, alpha, brain-specific; unnamed protein product
基因别名: B-ALPHA-1; LIS3; Tuba-1; Tuba1; TUBA1A; TUBA3
UniProt ID: (Human) Q71U36, (Mouse) P68369, (Rat) P05210
Entrez Gene ID: (Human) 7846, (Mouse) 22142, (Rat) 64158